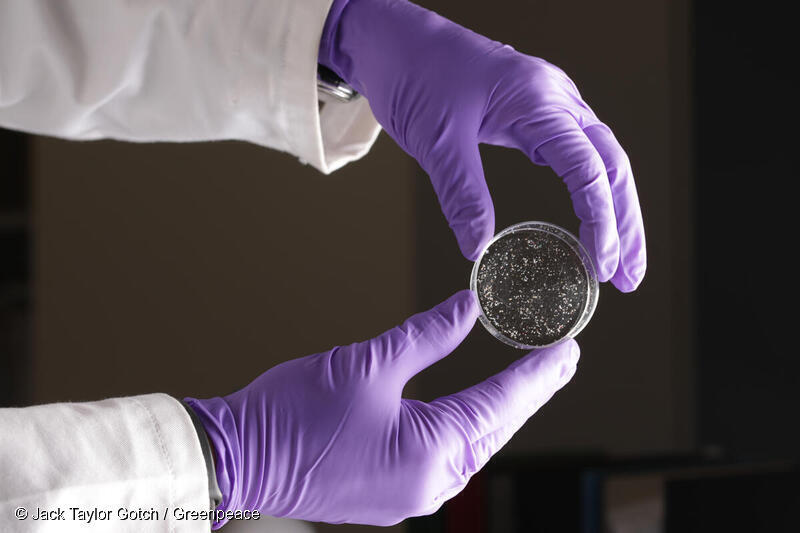

【専門家の解説】電子レンジ加熱で数十万個のプラスチックが溶け出す?研究が示す健康リスク
仕事帰りに買うコンビニ弁当、忙しい日の冷凍食品、子どもに手軽に出せるレトルト食品。あなたは今日、何を電子レンジで温めましたか?
忙しい毎日の食卓を支える調理済み食品ですが、これらをプラスチック容器に入れたまま電子レンジ加熱すると、マイクロプラスチックや有害な化学物質が食品に溶け出すという衝撃的な事実が、これまでに発表されている科学文献を分析したグリーンピースの調査で明らかになりました。
このブログでは調査の内容と、プラスチックの研究者・高田秀重教授の知見をもとに、プラスチックがもたらす健康リスクと対策を解説します。
この投稿を読むとわかること
プラスチック容器の電子レンジ加熱は安全なの?

グリーンピースは2月、プラスチック容器に入った調理済み食品の健康リスクに関して、査読付き論文24本を検証した報告書『Are We Cooked? The Hidden Health Risks of Plastic-Packaged Ready Meals』(プラスチック包装の調理済み食品に潜む健康リスク)を発表しました。
24本の文献を精査した結果、衝撃的な事実が浮かび上がりました。プラスチック容器に食品を入れて電子レンジで加熱すると、数十万個ものマイクロプラスチックや100種類を超える有害な化学物質が食品中に溶け出すことが明らかになったのです。
便利ですぐに食べられる調理済み食品は、もはや私たちの食卓に欠かせないものです。2024年の生産量は世界全体で7,100万トン(1人あたりの消費量は平均12.6kg)にものぼり、今後も増加が見込まれています。ですが、こうした便利さの裏で私たちは大きなリスクにさらされています。
マイクロプラスチックとともに溶け出す有害な化学物質
ある文献では、ポリプロピレン製の容器をわずか5分間電子レンジ加熱するだけで、最大53万4,000個のマイクロプラスチックが溶出したと推定されています。この量はオーブン加熱と比較して4〜7倍にもなります。
研究者たちは、電子レンジ特有の振動がオーブン加熱より多くのマイクロプラスチックを溶出させると分析し、出力が高く加熱時間が長いほどその量を増加させるということも明らかになっています。
さらに深刻なのがプラスチックとともに溶け出す有害な化学物質です。プラスチックは原料そのものが化石燃料由来の化学物質ですが、それだけでなく製造過程で意図的に添加された可塑剤・安定剤などの添加剤、加熱や劣化などにより意図せず生成された化学物質など、16,000種以上の化学物質がプラスチック製品から検出されています。こうした化学物質のうち少なくとも4,200種は人体・環境への有害性が確認されています。
今回グリーンピースが検証した文献の1つでは添加剤40種に加え、非意図的に生成された化学物質100種以上が電子レンジ加熱により溶け出したことがわかりました。
日本ではどうなの?高田教授が語るプラスチックケミカルズの危険
日本を代表するマイクロプラスチック汚染の研究者である高田秀重教授は、これらの化学物質を総称する「プラスチックケミカルズ」について警鐘を鳴らしています。
高田教授はグリーンピースの報告書にコメントを寄せ、「プラスチック製品を飲食物の容器に使えば何らかのプラスチックケミカルズに曝露されるため、プラスチックに包まれた食品をできる限り避けるべき」と訴えました。
2022年の研究では、国内で市販されているプラスチック製品48種のうちコンビニのスチロール製お椀、カップ麺容器、ストローなどを含む40種からプラスチックケミカルズが検出されています*1。
別の研究では密閉性食品保存容器などにも使用されるポリプロピレン製のプラスチック容器から、魚類に対する毒性が報告されている酸化防止剤が検出されたり*2、生鮮食品によく使用されるスチロール製の食品トレーから発がん性のある物質が検出されたりしています*3 。

プラスチックケミカルズは水より油に溶けやすい性質があるため、コンビニ弁当などをプラスチック容器のまま電子レンジで温めることは特に危険だと高田教授は言います。また「これらの添加剤には表示義務がなく、非意図的に生成された化学物質はメーカーすら把握できていない」と、その見えない危険性を指摘します。
プラスチックケミカルズがもたらす健康リスク
プラスチックケミカルズはすでに1,396種が人の血液・脂肪組織・肝臓から検出されています。
高田教授らは、ビスフェノールAという有害な化学物質をヒトのへその緒から検出しました。ビスフェノールAは食品容器などから幅広く検出されますが、内分泌かく乱物質(環境ホルモン)として生殖や子供の発達に悪影響を及ぼすことが明らかになっています。

「プラスチックケミカルズは分子量が小さく、生物の組織に容易に浸透する」と高田教授は言います。なかには女性ホルモンと結合するものがあり、性や生殖に関する異常を引き起こす可能性があると指摘します。
環境省が全国約10万人の妊婦を対象に行った「エコチル調査」では、使い捨てプラスチック容器に入った弁当や冷凍食品を週1回以上食べた妊婦の死産割合は、そうでない妊婦の2.6倍高かったと報告されています*4。
もちろん、身体の異常とその原因物質などの要因を特定することは困難ですが、複数の疫学調査からプラスチックを柔らかくするフタル酸エステル類(可塑剤)、ビスフェノール類、そして「永遠の化学物質」と呼ばれるPFAS(有機フッ素化合物)といった化学物質は、ホルモンかく乱物質として作用し、生殖異常などの健康影響も確認されています。
【研究で懸念が示されている化学物質とその健康影響】
| 化学物質 | 主な用途 | 人体・環境への主なリスク |
|---|---|---|
| ビスフェノールA(BPA) | 樹脂の原料。可塑剤としても使用。 | 水生生物への毒性が高く、内分泌かく乱物質として作用。 |
| アルキルフェノール類(APs/APEs) | 樹脂の原料。可塑剤としても使用されるほか、プラスチックの酸化防止剤の副産物としても検出される。 | 内分泌かく乱の疑い。乳がん・前立腺がん・子宮内膜症・心臓病・糖尿病・免疫異常・脳発達への影響との関連が指摘。 |
| フタル酸エステル類 | プラスチックコーティングの軟化剤(可塑剤)。 | 生殖へ毒性あり。EUでは「高懸念物質」に指定されているものも多い。 |
| 有機フッ素化合物 (PFAS) | 撥水・撥油コーティング剤。紙・段ボール製食品容器にも使用。 | 自然界で分解されず、永遠の化学物質と呼ばれる。生殖・成長ホルモンへの影響が指摘。 |
| 臭素系難燃剤(PBDEs) | 一部プラスチックの難燃剤として添加。 | 残留性・生物濃縮性が高く、内分泌かく乱物質として作用。 |
| 多環芳香族炭化水素 (PAHs) | ゴムやプラスチックへの軟化剤・増量剤として添加。 | 発がん性あり。長期曝露で特定のがんリスクが上昇。世界の主要市場で最終製品への含有が規制。 |
| トリクロサン (別名:マイクロバン) | 抗菌剤として添加。 | 内分泌かく乱物質。免疫・心血管機能に影響する可能性あり。乳幼児の生殖・発達異常との関連も。EUでは認可リストから削除済みだが米国等では使用継続中。 |
| アンチモン | PETプラスチック(ペットボトル・ポリエステル)製造の触媒 | 毒性が高く、呼吸器・皮膚・免疫系への影響が確認されている |
今日から実践できる、リスクを減らす5つの行動

プラスチックを完全に排除することは困難ですが、プラスチックと食品の接触をできるだけ避けることで、体内に取り込まれる量を大幅に減らすことは可能です。
【今日からできる対策】
- プラスチック容器に入った調理済みの食品やテイクアウトを購入した場合は、電子レンジ加熱前にガラスや陶器などの耐熱容器を移し替える
- プラスチックラップをかけたまま加熱しない
- 熱い食品をプラスチック容器に直接入れない
- 可能な場合は、プラスチック以外のリユース可能な容器を使用する
- 地元のスーパーやレストラン、お店に、プラスチックの使用を減らし、より安全な代替手段を提供してもらうよう働きかける
グリーンピースは実生活の中でプラスチック消費を減らすヒントなどをまとめた「エコなくらし 実施ガイド」を準備しました。ぜひこちらをダウンロードして、暮らしを見直してみませんか?
日本の規制は不十分。規制対象外の化学物質とは?
日本では、「食品用器具・容器包装のポジティブリスト制度」のリストに記載された添加剤のみが、食品接触プラスチックへ配合を許可されています。
この制度は個々の化学物質について添加可能量を設定しているものの、複数の化学物質が同時に添加されたケースを想定していません。
高田教授は「複数の化学物質の複合的な曝露という21世紀の化学物質汚染に対応した規制になっていない」と指摘します。
それだけでなく、人間の健康に悪影響を及ぼすことが分かっているノニルフェノール、Irgafos168酸化体など、添加剤やポリマーの分解などにより意図せず生成された化学物質がポジティブリストの対象外となっていることにも懸念を示しています。

マイクロプラスチックや化学物質の問題は個人の対策だけでは解決できません。
プラスチック包装されてない商品を選ぶなど個人の努力でプラスチックを避けようとしても、多くの食材や商品はプラスチックで梱包されています。
さらにこうしたプラスチックが廃棄後に埋め立てられれば、化学物質が地中に溶け出して河川や海を汚染し、焼却されればダイオキシン等の有害物質が発生する上に気候変動へも悪影響を及ぼします。リサイクルの過程で、意図せずプラスチックケミカルズが混入するリスクも考えられます。食品容器・包装に使われるプラスチックの削減が必要です。
容器包装資材はプラスチック廃棄物の約40%*5を占めているので、その削減はプラスチック問題全体への貢献も大きいです。ではどのように削減していったらよいのでしょうか?
高田教授は「社会経済システムをグローバル化経済から地域資源循環経済へ変革し、地域内で生産・消費することで、包装資材の量自体を減らすことができる」と訴えます。その上で、必要な容器包装資材はプラスチックをやめて、繰り返し使用可能な金属、ガラス、陶器等に変えたり、はだか売りの商品を選んだりすることも重要です。
社会を動かすグリーンピースの活動
これほど明確なリスクがあるにもかかわらず、なぜプラスチックや危険な化学物質の規制は進まないのでしょうか。
過去にも健康被害をもたらしたタバコやアスベスト、鉛で同様の問題が起きました。いずれも「科学的に不確定だ」という産業界の主張によって規制が何十年も遅れたのです。

プラスチックも今、同じ構造にあります。国際的なプラスチック規制の枠組み作りを目指す国際プラスチック条約の交渉の場には、プラスチックの原料となる化石燃料業界や化学業界から数百人ものロビイストが押しかけ、「経済に悪影響が出る」と規制の回避を訴えています。
グリーンピースはこの条約に対し、2040年までにプラスチック生産量を少なくとも75%削減すること、使い捨てプラスチック包装の禁止、有害化学物質の段階的廃止などを盛り込むよう求めています。
脱プラスチック社会の実現に向けて、一刻も早い枠組みの完成を目指し活動を続けていきます。
(本記事は、グリーンピース・インターナショナルによる報告書「Are We Cooked? The Hidden Health Risks of Plastic-Packaged Ready Meals」(2025年)、および東京農工大学・高田秀重教授による同報告書へのコメントをもとに作成しました。)
*1 坂根ら, 2022 : 第1回環境化学物質3学会合同大会要旨集 p.555-556
*2 河村ら, 2000. 食品用ポリプロピレン製品中の添加剤の分析. 食品衛生学雑誌 41, 154-161. 10.3358/shokueishi.41.154
*3 Yeo, B.G., et al., 2022. Polycyclic aromatic hydrocarbons (PAHs) in new unexposed and beached expanded polystyrene foams. Environmental Monitoring and Contaminants Research 2, 14-21. https://doi.org/10.5985/emcr.20210012
*4 Tamada, H., et al., 2022. Impact of Ready-Meal Consumption during Pregnancy on Birth Outcomes: The Japan Environment and Children’s Study. Nutrients 14, 895. https://doi.org/10.3390/nu14040895
*5 プラスチック循環利用協会「プラスチック製品の生産・廃棄・再資源化・処理処分の状況(マテリアルフロー図)」2024年